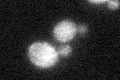
YDL107W
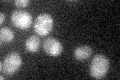
YDL107W

View description
Peripherally bound inner membrane protein of the mitochondrial matrix involved in membrane insertion of C-terminus of Cox2p, interacts genetically and physically with Cox18p
Localization:
Intensity:
Fold change:
Significance:
-
C’ GFP library in SD
mitochondria20.08 -
N' NOP1pr-GFP in SD

mitochondria70.0928 -
N' TEF2pr-mCherry in SD

missing0 -
N' NATIVEpr-GFP in SD

below threshold22.8464 -
N' TEF2pr-VC and Cyto-VN in SD

#N/A0 -
C’ GFP library in SD+DTT

mitochondria15.030.74No -
C’ GFP library in SD+H2O2

mitochondria16.270.81No -
C’ GFP library in Starvation Media
mitochondria24.091.19No -
C’ GFP library on the background of Pup2-DaMP

mitochondria -
C’ GFP library on the background of CCT mutant

mitochondria18.28510.910183No
